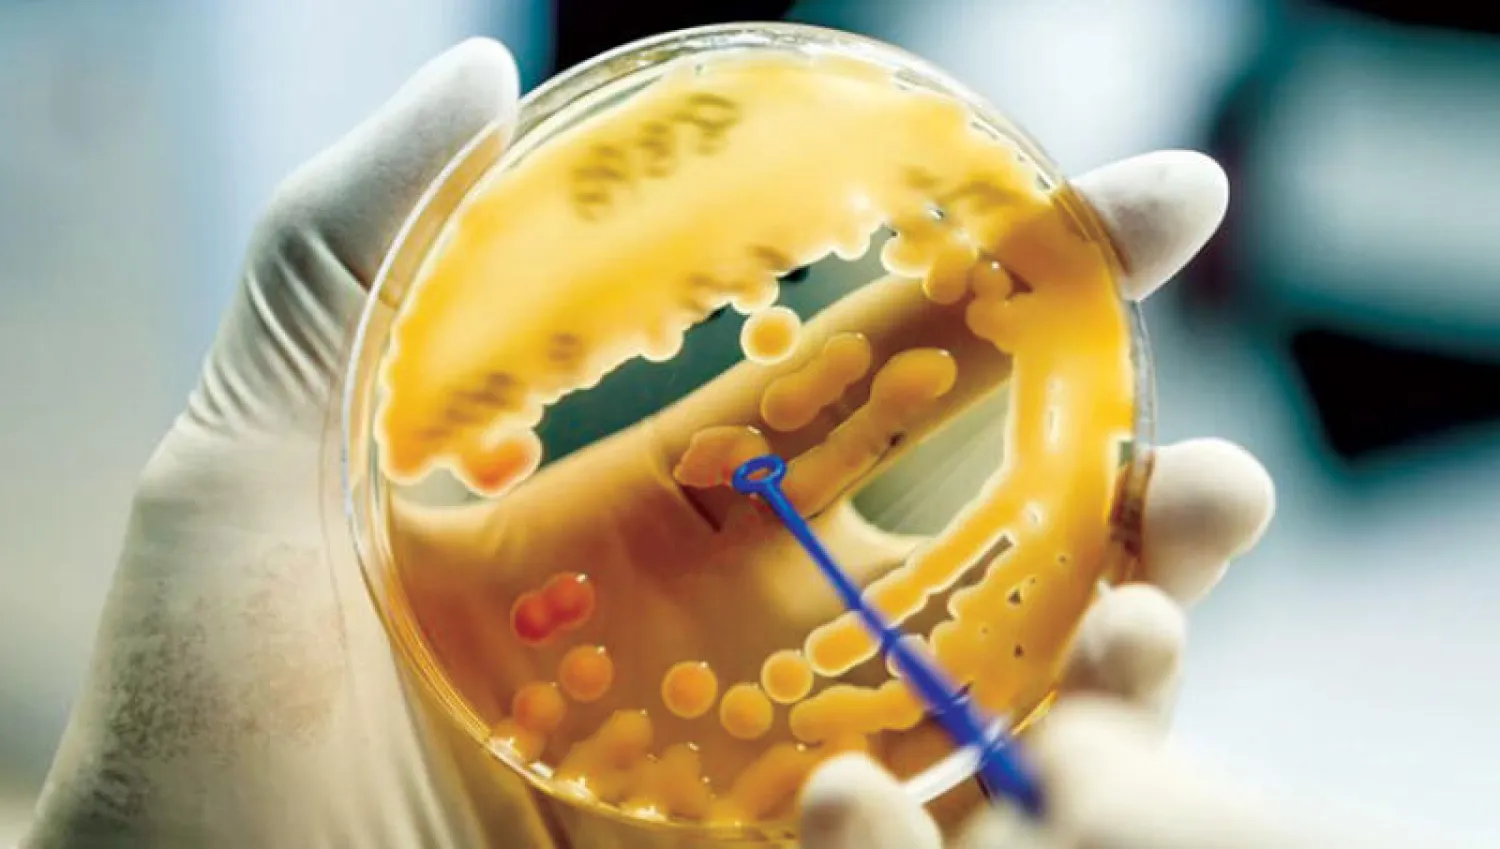
بكتيريا الكلبسيلة الرئوية حيرت العلماء لعقود

دفع الاستخدام غير المعقول للمضادات الحيوية البكتيريا لتطوير آليات مقاومة لهذا النوع من العلاج، وهي الظاهرة، المعروفة باسم «مقاومة المضادات الحيوية»، والتي تعتبرها منظمة الصحة العالمية، واحدة من أكبر التهديدات للصحة، حيث يمكن أن يعيدنا نقص العلاج ضد البكتيريا المقاومة، إلى زمن مات فيه ملايين الأشخاص بسبب الالتهاب الرئوي أو السالمونيلا.
وتعد بكتيريا «الكلبسيلة الرئوية»، وهي شائعة جداً في المستشفيات وخبيثة بشكل خاص، أحد مسببات الأمراض التي أصبحت أسلحتنا ضدها غير حادة، غير أن فريقا بحثيا من جامعة جنيف، اكتشف جزيئا مضادا للهربس يستخدم منذ الستينيات، يضعف السطح الوقائي لهذه البكتيريا ويسهل للخلايا المناعية مهمة القضاء عليها، وتم نشر هذه النتائج (السبت) في مجلة «بلوس وان».
وتسبب «الكلبسيلة الرئوية»، العديد من التهابات الجهاز التنفسي والأمعاء والمسالك البولية، ونظراً لمقاومتها لمعظم المضادات الحيوية الشائعة وقوتها العالية، يمكن أن تكون بعض سلالاتها قاتلة بنسبة 40 إلى 50 في المائة من المصابين، وهناك حاجة ملحة لتطوير جزيئات علاجية جديدة لمواجهتها، ومنذ الثلاثينيات، اعتمد الطب على المضادات الحيوية للتخلص من البكتيريا المسببة للأمراض، ولكن هناك طرق أخرى ممكنة، من بينها محاولة إضعاف نظام الدفاع للبكتيريا حتى لا تتمكن بعد الآن من الهروب من جهاز المناعة.
وأظهر الفريق البحثي من جامعة جنيف، أن هذا الطريق واعد للغاية لأن ضراوة «الكلبسيلة الرئوية» تنبع إلى حد كبير من قدرتها على تجنب هجمات جهاز المناعة.
10:33 دقيقه
دواء قديم لمحاربة البكتيريا المقاومة
https://aawsat.com/home/article/3973101/%D8%AF%D9%88%D8%A7%D8%A1-%D9%82%D8%AF%D9%8A%D9%85-%D9%84%D9%85%D8%AD%D8%A7%D8%B1%D8%A8%D8%A9-%D8%A7%D9%84%D8%A8%D9%83%D8%AA%D9%8A%D8%B1%D9%8A%D8%A7-%D8%A7%D9%84%D9%85%D9%82%D8%A7%D9%88%D9%85%D8%A9



دواء قديم لمحاربة البكتيريا المقاومة

بكتيريا الكلبسيلة الرئوية حيرت العلماء لعقود
- القاهرة: حازم بدر
- القاهرة: حازم بدر

دواء قديم لمحاربة البكتيريا المقاومة
بكتيريا الكلبسيلة الرئوية حيرت العلماء لعقود
مواضيع
مقالات ذات صلة
لم تشترك بعد
انشئ حساباً خاصاً بك لتحصل على أخبار مخصصة لك ولتتمتع بخاصية حفظ المقالات وتتلقى نشراتنا البريدية المتنوعة













